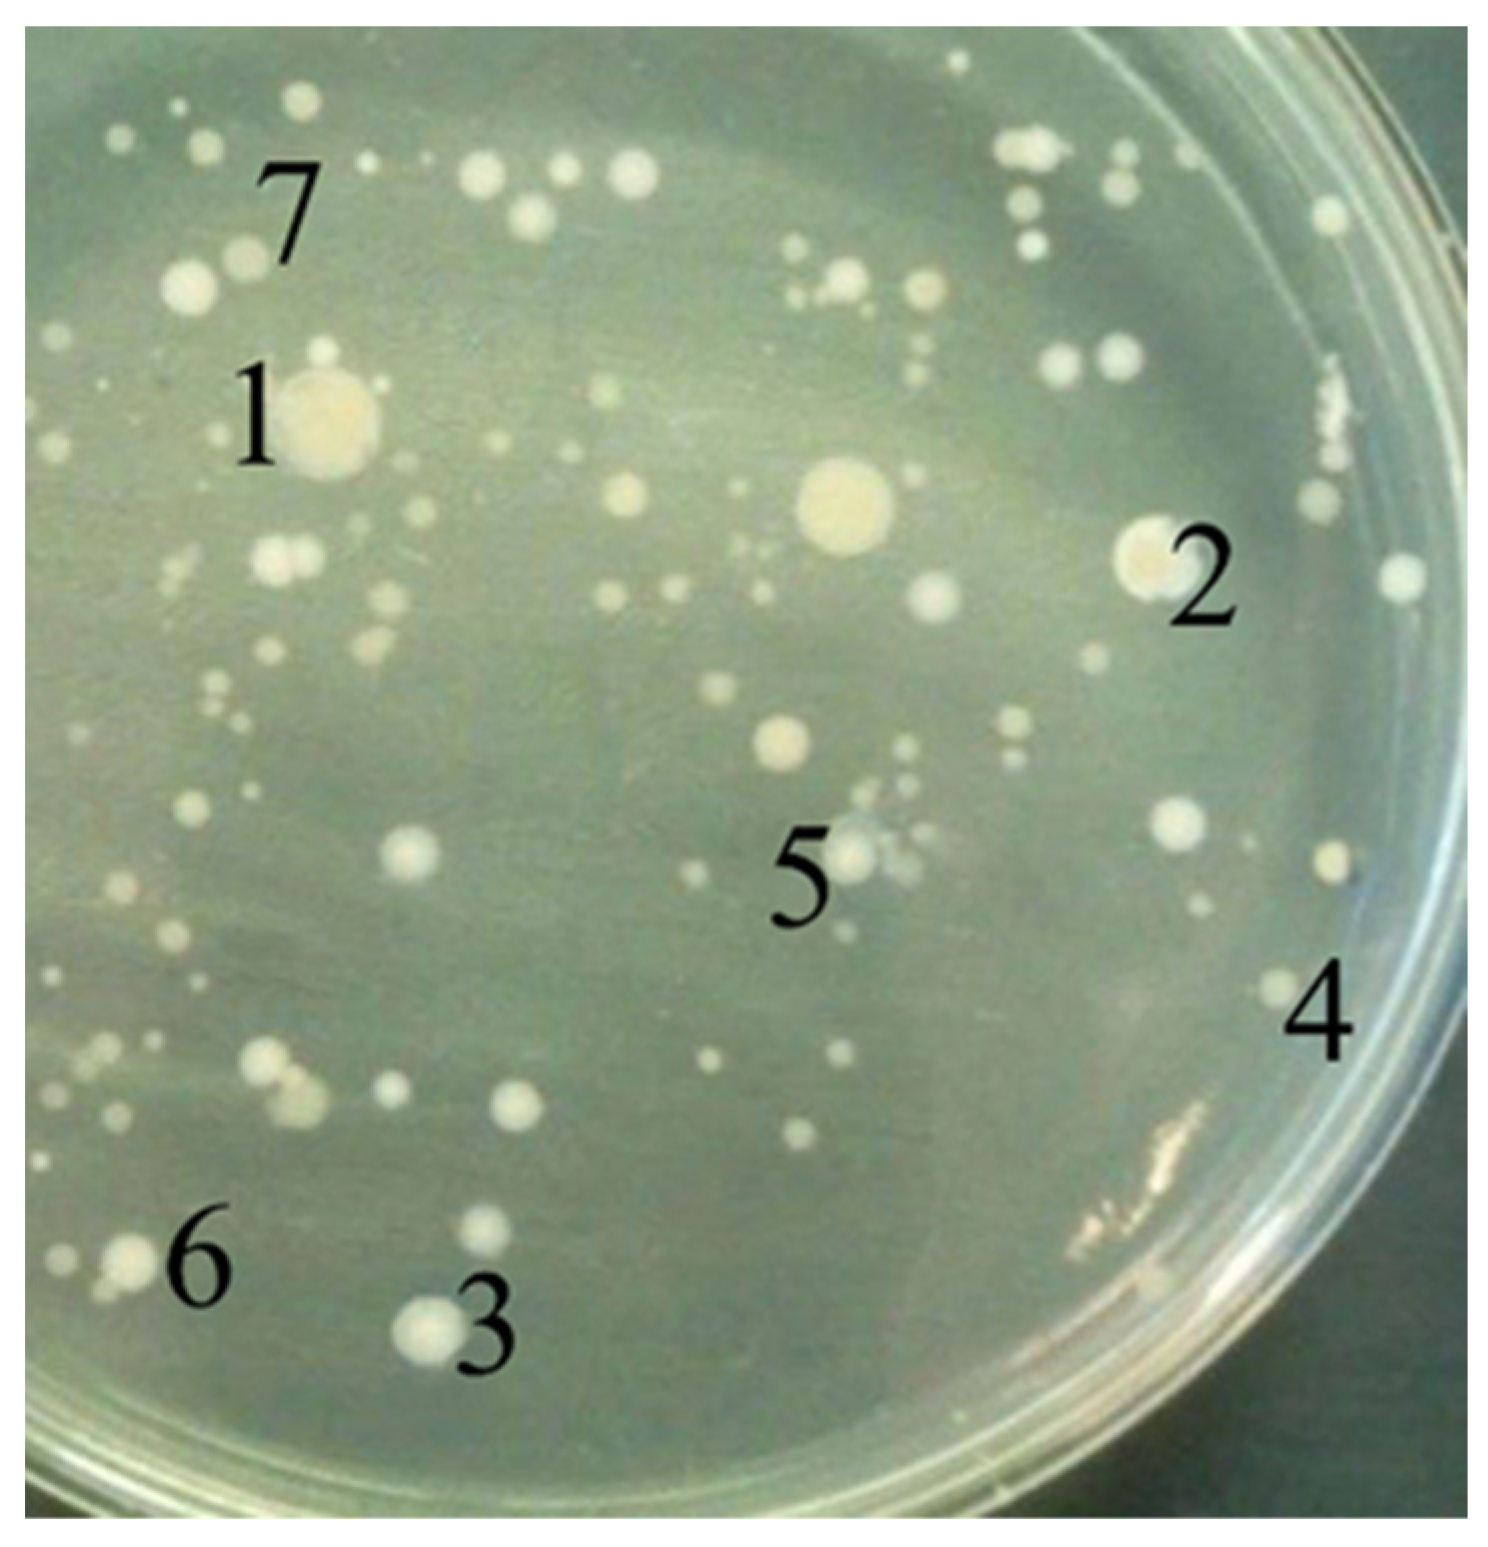
Biology 11 01332 g001

Didecyldimethylammonium Chloride- and Polyhexamethylene Guanidine-Resistant Bacteria Isolated from Fecal Sludge and Their Potential Use in Biological Products for the Detoxification of Biocide-Contaminated Wastewater Prior to Conventional Biological Treatment
Abstract
:Simple Summary
Abstract
1. Introduction
2. Materials and Methods
2.1. Fecal Sludge and Biocides
- -
- 20% aqueous solution of PHMG hydrochloride (biocide “Biopag D”, International Institute of Ecological and Technological Problems, LLC, Moscow, Russia);
- -
- 50% aqueous solution of ADBAC (biocide “Catamine AB”, Npao NPF Bursintez-M, Moscow, Russia);
- -
- 50% aqueous isopropanol solution of DDAC (biocide “SEPTAPAV HSV.50”, Scientific Manufacturing Enterprise «NIIPAV», Volgodonsk, Russia)
- -
- 20% aqueous solution of CHG (biocide “Dezin”, “Dezindustriya” LLC, Moscow, Russia).
2.2. Isolation of GAC- and PHMG-Resistant Microorganisms
2.3. Identification of Isolated Microorganisms
2.4. Cultivation
2.5. Determination of Minimum Inhibitory (MIC) and Bactericidal (MBC) Concentrations
2.6. Evaluation of the Effect of the Biocide “Latrina” on Bacterial Growth
2.7. Preparation of Biological Products Based on Isolated Bacterial Strains
2.8. Evaluation of the Effect of Biological Products on the Biodegradation of FS
2.9. Analytical Methods
2.10. Statistical Methods
3. Results
3.1. Isolation and Identification of Biocide-Resistant Microorganisms from FS
3.2. Resistance of the Isolated Strains to the Biocide “Latrina” Containing DDAC and PHMG
3.3. Biological Products Based on Isolated Bacterial Strains and Their Effect on the Bio-Degradation of FS
3.4. Effect of Bacterial Products on Detoxification of the Biocide “Latrina” in FS
4. Discussion
5. Conclusions
6. Patents
Author Contributions
Funding
Institutional Review Board Statement
Informed Consent Statement
Conflicts of Interest
References
- Schellenberg, T.; Subramanian, V.; Ganeshan, G.; Tompkins, D.; Pradeep, R. Wastewater discharge standards in the evolving context of urban sustainability—The case of India. Front. Environ. Sci. 2020, 8, 30. [Google Scholar] [CrossRef]
- Patel, A.; Arkatkar, A.; Singh, S.; Rabbani, A.; Solorza, M.J.D.; Ong, E.S.; Habashy, M.M.; Jadhav, D.A.; Rene, E.R.; Mungray, A.A.; et al. Physico-chemical and biological treatment strategies for converting municipal wastewater and its residue to resources. Chemosphere 2021, 282, 130881. [Google Scholar] [CrossRef]
- Yusuf, A.; O’Flynn, D.; White, B.; Holland, L.; Parle-McDermott, A.; Lawler, J.; McCloughlin, T.; Harold, D.; Huerta, B.; Regan, F. Monitoring of emerging contaminants of concern in the aquatic environment: A review of studies showing the application of effect-based measures. Anal. Methods 2021, 13, 5120–5143. [Google Scholar] [CrossRef]
- Wang, J.; Chen, Y.; Cai, P.; Gao, Q.; Zhong, H.; Sun, W.; Chen, Q. Impacts of municipal wastewater treatment plant discharge on microbial community structure and function of the receiving river in Northwest Tibetan Plateau. J. Hazard. Mater. 2022, 423, 127170. [Google Scholar] [CrossRef]
- Nagarkar, M.; Keely, S.P.; Brinkman, N.E.; Garland, J.L. Human- and infrastructure-associated bacteria in greywater. J. Appl. Microbiol. 2021, 131, 2178–2192. [Google Scholar] [CrossRef]
- Geng, H.; Xu, Y.; Zheng, L.; Gong, H.; Dai, L.; Dai, X. An overview of removing heavy metals from sewage sludge: Achievements and perspectives. Environ. Pollut. 2020, 266, 115375. [Google Scholar] [CrossRef]
- Liu, W.; Zhang, J.; Liu, H.; Guo, X.; Zhang, X.; Yao, X.; Cao, Z.; Zhang, T. A review of the removal of microplastics in global wastewater treatment plants: Characteristics and mechanisms. Environ. Int. 2021, 146, 106277. [Google Scholar] [CrossRef]
- Al Sharabati, M.; Abokwiek, R.; Al-Othman, A.; Tawalbeh, M.; Karaman, C.; Orooji, Y.; Karimi, F. Biodegradable polymers and their nano-composites for the removal of endocrine-disrupting chemicals (EDCs) from wastewater: A review. Environ. Res. 2021, 202, 111694. [Google Scholar] [CrossRef]
- Khurana, P.; Pulicharla, R.; Kaur Brar, S. Antibiotic-metal complexes in wastewaters: Fate and treatment trajectory. Environ. Int. 2021, 157, 106863. [Google Scholar] [CrossRef]
- Nguyen, P.Y.; Carvalho, G.; Reis, M.A.M.; Oehmen, A. A review of the biotransformations of priority pharmaceuticals in biological wastewater treatment processes. Water Res. 2021, 188, 116446. [Google Scholar] [CrossRef]
- Rathi, B.S.; Kumar, P.S.; Vo, D.N. Critical review on hazardous pollutants in water environment: Occurrence, monitoring, fate, removal technologies and risk assessment. Sci. Total Environ. 2021, 797, 149134. [Google Scholar] [CrossRef] [PubMed]
- Bureš, F. Quaternary Ammonium Compounds: Simple in Structure, Complex in Application. Top. Curr. Chem. 2019, 377, 14. [Google Scholar] [CrossRef] [PubMed]
- Maraldi, M.; Lisi, M.; Moretti, G.; Sponchioni, M.; Moscatelli, D. Health care-associated infections: Controlled delivery of cationic antiseptics from polymeric excipients. Int. J. Pharm. 2021, 607, 120956. [Google Scholar] [CrossRef] [PubMed]
- Minbiole, K.P.C.; Jennings, M.C.; Ator, L.E.; Black, J.W.; Grenier, M.C.; LaDow, J.E.; Caran, K.L.; Seifert, K.; Wuest, W.M. From antimicrobial activity to mechanism of resistance: The multifaceted role of simple quaternary ammonium compounds in bacterial eradication. Tetrahedron 2016, 72, 3559–3566. [Google Scholar] [CrossRef]
- Brzozowski, P.; Penev, K.I.; Mequanint, K. Gellan gum gel tissue phantoms and gel dosimeters with tunable electrical, mechanical and dosimetric properties. Int. J. Biol. Macromol. 2021, 180, 332–338. [Google Scholar] [CrossRef] [PubMed]
- Obłąk, E.; Futoma-Kołoch, B.; Wieczyńska, A. Biological activity of quaternary ammonium salts and resistance of microorganisms to these compounds. World J. Microbiol. Biotechnol. 2021, 37, 22. [Google Scholar] [CrossRef] [PubMed]
- Jiao, Y.; Niu, L.N.; Ma, S.; Li, J.; Tay, F.R.; Chen, J.H. Quaternary ammonium-based biomedical materials: State-of-the-art, toxicological aspects and antimicrobial resistance. Prog. Polym. Sci. 2017, 71, 53–90. [Google Scholar] [CrossRef]
- Baker, N.; Williams, A.; Tropsha, A.; Ekins, S. Repurposing quaternary ammonium compounds as potential treatments for COVID-19. Pharm. Res. 2020, 37, 104. [Google Scholar] [CrossRef] [PubMed]
- Schrank, C.; Minbiole, K.; Wuest, W. Are quaternary ammonium compounds, the workhorse disinfectants, effective against severe acute respiratory syndrome-Coronavirus-2? ACS Infect. Dis. 2020, 6, 1553–1557. [Google Scholar] [CrossRef]
- Vereshchagin, A.N.; Frolov, N.A.; Egorova, K.S.; Seitkalieva, M.M.; Ananikov, V.P. Quaternary ammonium compounds (QACs) and ionic liquids (ILs) as biocides: From simple antiseptics to tunable antimicrobials. J. Mol. Sci. 2021, 22, 6793. [Google Scholar] [CrossRef]
- Verlag, G.T. Eine neue klasse von desinfektionsmitteln gerhard domagk. Dtsch. Med. Wochenschr. 1935, 61, 829–832. [Google Scholar] [CrossRef]
- Labena, A.; Hegazy, M.; Sami, R.; Hozzein, W. Multiple applications of a novel cationic gemini surfactant: Anti-microbial, anti-biofilm, biocide, salinity corrosion inhibitor, and biofilm dispersion (Part II). Molecules 2020, 25, 1348. [Google Scholar] [CrossRef]
- Fjeld, H.; Lingaas, E. Polyhexanide-safety and efficacy as an antiseptic. Tidsskr. Nor. Laegeforen. 2016, 136, 707–711. [Google Scholar] [CrossRef]
- Jones, I.A.; Joshi, L.T. Biocide Use in the Antimicrobial Era: A Review. Molecules 2021, 26, 2276. [Google Scholar] [CrossRef]
- Karpiński, T.M.; Szkaradkiewicz, A.K. Chlorhexidine--pharmaco-biological activity and application. Eur. Rev. Med. Pharmacol. Sci. 2015, 19, 1321–1326. [Google Scholar] [PubMed]
- Wade, R.G.; Burr, N.E.; McCauley, G.; Bourke, G.; Efthimiou, O. The Comparative efficacy of chlorhexidine gluconate and povidone-iodine antiseptics for the prevention of infection in clean surgery: A systematic review and network meta-analysis. Ann. Surg. 2021, 274, 481–488. [Google Scholar] [CrossRef]
- Noll, C.V.; Kilcoyne, I.; Nieto, J.E.; Thio, T.; Byrne, B.A. In vitro efficacy of a 0.2% polyhexamethylene biguanide-impregnated gauze dressing against pathogenic bacterial isolates found in horses. Vet. Surg. 2021, 50, 880–887. [Google Scholar] [CrossRef] [PubMed]
- Keerthisinghe, T.P.; Nguyen, L.N.; Kwon, E.E.; Oh, S. Antiseptic chlorhexidine in activated sludge: Biosorption, antimicrobial susceptibility, and alteration of community structure. J. Environ. Manag. 2019, 237, 629–635. [Google Scholar] [CrossRef] [PubMed]
- Wang, W.; Yim, S.L.; Wong, C.H.; Kan, C.W. Study on the development of antiviral spandex fabric coated with poly(hexamethylene biguanide) hydrochloride (PHMB). Polymers 2021, 13, 2122. [Google Scholar] [CrossRef]
- Cieplik, F.; Jakubovics, N.S.; Buchalla, W.; Maisch, T.; Hellwig, E.; Al-Ahmad, A. Resistance toward chlorhexidine in oral bacteria–is there cause for concern? Front. Microbiol. 2019, 10, 587. [Google Scholar] [CrossRef] [Green Version]
- Chindera, K.; Mahato, M.; Sharma, A.K.; Horsley, H.; Kloc-Muniak, K.; Kamaruzzaman, N.F.; Kumar, S.; McFarlane, A.; Stach, J.; Bentin, T.; et al. The antimicrobial polymer PHMB enters cells and selectively condenses bacterial chromosomes. Sci. Rep. 2016, 6, 23121. [Google Scholar] [CrossRef]
- DeLeo, P.C.; Huynh, C.; Pattanayek, M.; Schmid, K.C.; Pechacek, N. Assessment of ecological hazards and environmental fate of disinfectant quaternary ammonium compounds. Ecotoxicol. Environ. Saf. 2020, 206, 111116. [Google Scholar] [CrossRef]
- Luz, A.; DeLeo, P.; Pechacek, N.; Freemantle, M. Human health hazard assessment of quaternary ammonium compounds: Didecyl dimethyl ammonium chloride and alkyl (C12-C16) dimethyl benzyl ammonium chloride. Regul. Toxicol. Pharmacol. 2020, 116, 104717. [Google Scholar] [CrossRef]
- Lee, J.; Choi, S.J.; Jeong, J.S.; Kim, S.Y.; Lee, S.J.; Baek, S.K.; Kwon, N.; Lee, S.H.; Kim, W.; Cho, J.W.; et al. Adverse postnatal developmental effects in offspring from humidifier disinfectant biocide inhaled pregnant rats. Chemosphere 2022, 286, 131636. [Google Scholar] [CrossRef]
- Zakharova, L.Y.; Pashirova, T.N.; Doktorovova, S.; Fernandes, A.R.; Sanchez-Lopez, E.; Silva, A.M.; Souto, S.B.; Souto, E.B. Cationic Surfactants: Self-Assembly, Structure-Activity Correlation and Their Biological Applications. Int. J. Mol. Sci. 2019, 20, 5534. [Google Scholar] [CrossRef]
- Chang, F.; Shen, S.; Shi, P.; Zhang, H.; Ye, L.; Zhou, Q.; Pan, Y.; Li, A. Antimicrobial resins with quaternary ammonium salts as a supplement to combat the antibiotic resistome in drinking water treatment plants. Chemosphere 2019, 221, 132–140. [Google Scholar] [CrossRef]
- Zander, Z.K.; Chen, P.; Hsu, Y.H.; Dreger, N.Z.; Savariau, L.; McRoy, W.C.; Cerchiari, A.E.; Chambers, S.D.; Barton, H.A.; Becker, M.L. Post-fabrication QAC-functionalized thermoplastic polyurethane for contact-killing catheter applications. Biomaterials 2018, 178, 339–350. [Google Scholar] [CrossRef]
- Hübner, N.-O.; Kramer, A. Review on the efficacy, safety and clinical applications of polihexanide, a modern wound antiseptic. Ski. Pharmacol. Physiol. 2010, 23, 17–27. [Google Scholar] [CrossRef]
- Hoang, T.P.N.; Ghori, M.U.; Conway, B.R. Topical antiseptic formulations for skin and soft tissue infections. Pharmaceutics 2021, 13, 558. [Google Scholar] [CrossRef]
- Park, Y.J.; Jeong, M.H.; Bang, I.J.; Kim, H.R.; Chung, K.H. Guanidine-based disinfectants, polyhexamethylene guanidine-phosphate (PHMG-P), polyhexamethylene biguanide (PHMB), and oligo(2-(2-ethoxy)ethoxyethyl guanidinium chloride (PGH) induced epithelial-mesenchymal transition in A549 alveolar epithelial cells. Inhal Toxicol. 2019, 31, 161–166. [Google Scholar] [CrossRef]
- Wahid, M.B.; Samir, Y.A.; Khairy, A.M.E.; Eman, A.Y.; Sanaa, A.A.; Hanan, F.A. Synthesis and hyperglycemic, biochemical and histopathological evaluation of novel sulfonylbiguanide and sulfonylurea derivatives as potent anti-diabetic agents. Bioorganic Chem. 2021, 117, 105418. [Google Scholar] [CrossRef]
- Litti, Y.V.; Serdyukov, D.V.; Kanunnikov, O.V.; Akselrod, V.A.; Loiko, N.G. Antimicrobial properties of a biocide based on quaternary ammonium compounds plus polyhexamethylene guanidine and possible methods for its deactivation. Appl. Biochem. Microbiol. 2021, 57, 962–972. [Google Scholar] [CrossRef]
- Litti, Y.; Serdyukov, D.; Kanunnikov, O.; Axelrod, V.; Loiko, N. Treatment of Preserved Fecal Sludge Using Anaerobic Digestion. Ecol. Ind. Russ. 2020, 24, 33–37. [Google Scholar] [CrossRef]
- Sozzi, E.; Baloch, M.; Strasser, J.; Fisher, M.B.; Leifels, M.; Camacho, J.; Mishal, N.; Elmes, S.F.; Allen, G.; Gregory, G.; et al. A bioassay-based protocol for chemical neutralization of human faecal wastes treated by physico-chemical disinfection processes: A case study on benzalkonium chloride. Int. J. Hyg. Environ. Health 2019, 222, 155–167. [Google Scholar] [CrossRef]
- Ismail, Z.Z.; Tezel, U.; Pavlostathis, S.G. Sorption of quaternary ammonium compounds to municipal sludge. Water Res. 2010, 44, 2303–2313. [Google Scholar] [CrossRef]
- Rajasulochana, P.; Preethy, V. Comparison on efficiency of various techniques in treatment of waste and sewage water–A comprehensive review. Resour.-Effic. Technol. 2016, 2, 175–184. [Google Scholar] [CrossRef]
- Pradhan, S.; Hoover, M.T.; Clark, G.H.; Gumpertz, M.; Cobb, C.; Strock, J. Impacts of biological additives, part 1: Solids accumulation in septic tanks. J. Environ. Health 2011, 74, 16–21. [Google Scholar]
- Tang, H.L.; Xie, Y.F.; Chen, Y.C. Use of Bio-Amp, a commercial bio-additive for the treatment of grease trap wastewater containing fat, oil and grease. Bioresour. Technol. 2012, 124, 52–58. [Google Scholar] [CrossRef]
- Pradhan, S.; Hoover, M.T.; Clark, G.H.; Gumpertz, M.; Wollum, A.G.; Cobb, C.; Strock, J. Septic tank additive impacts on microbial populations. J. Environ. Health 2008, 70, 22–27. [Google Scholar]
- Lever, M.A.; Torti, A.; Eickenbusch, P.; Michaud, A.B.; Šantl-Temkiv, T.; Jørgensen, B.B. A modular method for the extraction of DNA and RNA, and the separation of DNA pools from diverse environmental sample types. Front. Microbiol. 2015, 6, 476. [Google Scholar] [CrossRef]
- Fadrosh, D.W.; Ma, B.; Gajer, P.; Sengamalay, N.; Ott, S.; Brotman, R.M.; Ravel, J. An improved dual-indexing approach for multiplexed 16S rRNA gene sequencing on the Illumina MiSeq platform. Microbiome 2014, 2, 6. [Google Scholar] [CrossRef]
- Caporaso, J.G.; Lauber, C.L.; Walters, W.A.; Berg-Lyons, D.; Huntley, J.; Fierer, N.; Owens, S.M.; Betley, J.; Fraser, L.; Bauer, M.; et al. Ultra-high-throughput microbial community analysis on the Illumina HiSeq and MiSeq platforms. Microb. Ecol. Funct. Divers. Nat. Habitats 2012, 6, 1621–1624. [Google Scholar] [CrossRef] [Green Version]
- Caporaso, J.G.; Kuczynski, J.; Stombaugh, J.; Bittinger, K.; Bushman, F.D.; Costello, E.K.; Fierer, N.; Peña, A.G.; Goodrich, J.K.; Gordon, J.I.; et al. QIIME allows analysis of high-throughput community sequencing data. Nat. Methods 2010, 7, 335–336. [Google Scholar] [CrossRef]
- Quast, C.; Pruesse, E.; Yilmaz, P.; Gerken, J.; Schweer, T.; Yarza, P.; Peplies, J.; Glöckner, F.O. The SILVA ribosomal RNA gene database project: Improved data processing and web-based tools. Nucleic Acids Res. 2013, 41, D590–D596. [Google Scholar] [CrossRef]
- Lokshina, L.; Vavilin, V.; Litti, Y.; Glagolev, M.; Sabrekov, A.; Kotsyurbenko, O.; Kozlova, M. Methane Production in a West Siberian Eutrophic Fen Is Much Higher than Carbon Dioxide Production: Incubation of Peat Samples, Stoichiometry, Stable Isotope Dynamics, Modeling. Water Resour. 2019, 46, 110–125. [Google Scholar] [CrossRef]
- Zhou, Z.; Wei, D.; Lu, Y. Polyhexamethylene guanidine hydrochloride shows bactericidal advantages over chlorhexidine digluconate against ESKAPE bacteria. Biotechnol. Appl. Biochem. 2015, 62, 268–274. [Google Scholar] [CrossRef]
- Gerba, C.P. Quaternary ammonium biocides: Efficacy in application. Appl. Environ. Microbiol. 2015, 81, 464–469. [Google Scholar] [CrossRef]
- Mostafa, A.; Mostafa, M.; El-Zanfaly, H.T.; Fahim, I. Effect of bacterial additives on the performance of septic tanks for wastewater treatment in the Upper Egypt rural area. WIT Trans. Ecol. Environ. 2010, 142, 389–400. [Google Scholar]
- Chen, H.; Wang, Y.; Lv, Y.K. Simultaneous removal characteristics of ammonium and phenol by Alcaligenes faecalis strain WY-01 with the addition of acetate. Bioprocess. Biosyst. Eng. 2021, 44, 27–38. [Google Scholar] [CrossRef]
- Basharat, Z.; Yasmin, A.; He, T.; Tong, Y. Genome sequencing and analysis of Alcaligenes faecalis subsp. phenolicus MB207. Sci. Rep. 2018, 8, 3616. [Google Scholar] [CrossRef]
- Anderes, E.A. Lipids of antibiotic-sensitive and -resistant strains of Pseudomonas aeruginosa. Can. J. Microbiol. 1971, 17, 1357–1365. [Google Scholar] [CrossRef] [PubMed]
- Jones, M.; Herd, T.; Christie, H. Resistance of Pseudomonas aeruginosa to amphoteric and quaternary ammonium biocides. Microbios 1989, 58, 49–61. [Google Scholar]
- Sakagami, Y.; Yokoyama, H.; Nishimura, H.; Ose, Y.; Tashima, T. Mechanism of resistance to benzalkonium chloride by Pseudomonas aeruginosa. Appl. Environ. Microbiol. 1989, 55, 2036–2040. [Google Scholar] [CrossRef]
- Mechin, L.; Dubois-Brissonet, F.; Heyd, B.; Leveau, J.Y. Adaptation of Pseudomonas aeruginosa ATCC 15442 to didecyldimethylammonium bromide induces changes in membrane fatty acid composition and in resistance of cells. J. Appl. Microbiol. 1999, 86, 859–866. [Google Scholar] [CrossRef] [PubMed]
- Langsrud, S.; Sundheim, G.; Borgmann-Strahsen, R. Intrinsic and acquired resistance to quaternary ammonium compounds in food-related Pseudomonas spp. J. Appl. Microbiol. 2003, 95, 874–882. [Google Scholar] [CrossRef] [PubMed]
- Neethu, S.; Vishnupriya, S.; Mathew, J. Isolation and functional characterisation of endophytic bacterial isolates from curcuma longa. Int. J. Pharm. Biol. Sci. 2016, 7, 455–464. [Google Scholar]
- Abdel Latef, A.A.H.; Omer, A.M.; Badawy, A.A.; Osman, M.S.; Ragaey, M.M. Strategy of Salt Tolerance and Interactive Impact of Azotobacter chroococcum and/or Alcaligenes faecalis Inoculation on Canola (Brassica napus L.) Plants Grown in Saline Soil. Plants 2021, 10, 110. [Google Scholar] [CrossRef]
- Akhtar, S.; Ali, B. Evaluation of rhizobacteria as non-rhizobial inoculants for mung beans. Aust. J. Crop. Sci. 2011, 5, 1723. [Google Scholar]
- Omer, A.M. Inducing plant resistance against salinity using some rhizobacteria. Egypt. J. Desert Res. 2017, 67, 187–208. [Google Scholar] [CrossRef]
- Mastan, A.; Rane, D.; Dastager, S.G.; Vivek Babu, C.S. Plant Probiotic Bacterial Endophyte, Alcaligenes faecalis, Modulates Plant Growth and Forskolin Biosynthesis in Coleus forskohlii. Probiotics Antimicrob Proteins 2020, 12, 481–493. [Google Scholar] [CrossRef]

| No | Isolated Strains | Genbank Accession Number |
|---|---|---|
| 1 | Paenalcaligenes sp. DOS1 | OL454899 |
| 2 | Staphylococcus pasteuri DOS2 | OL454901 |
| 3 | Enterococcus faecium DOS3 | OL454902 |
| 4 | Micrococcus endophyticus DOS4 | OL454903 |
| 5 | Enterococcus casseliflavus DOS5 | OL454904 |
| 6 | Bacillus subtilis DOS6 | OL454905 |
| 7 | Alcaligenes faecalis DOS7 | OL454906 |
| No | Microorganism | MIC, ppm | MBC, ppm |
|---|---|---|---|
| Isolated Strains | |||
| 1 | Paenalcaligenes sp. DOS1 | 150 | 400 |
| 2 | Staphylococcus pasteuri DOS2 | 16 | 32 |
| 3 | Enterococcus faecium DOS3 | 10 | 15 |
| 4 | Micrococcus endophyticus DOS4 | 45 | 70 |
| 5 | Enterococcus casseliflavus DOS5 | 10 | 15 |
| 6 | Bacillus subtilis DOS6 | 35 | 70 |
| 7 | Alcaligenes faecalis DOS7 | 1350 | 2700 |
| Collection Strains | |||
| 8 | Staphylococcus aureus 209P | 3.5 | 7.0 |
| 9 | Pseudomonas aeruginosa 4.8.1 | 105 | 140 |
| 10 | Bacillus subtilis 720 | 3.5 | 7.0 |
| 11 | Enterococcus faecium M | 2.0 | 4.0 |
| 12 | Micrococcus luteus NCIMB 13267 | 7.0 | 14.0 |
| Isolated Strains | The Total Concentration of DDAC and PHMG in the Nutrient Medium, ppm | |||
|---|---|---|---|---|
| 0 | 3.5 | 7 | 14 | |
| Paenalcaligenes sp. DOS1 | (2.2 ± 0.4)·109 (100) | (2.7 ± 0.4)·108 (12.3) | (1.9 ± 0.4)·108 (8.6) | (1.1 ± 0.4)·108 (5.0) |
| Staphylococcus pasteuri DOS2 | (1.5 ± 0.1)·109 (100) | (3.6 ± 0.2)·108 (24.0) | (1.9 ± 0.1)·108 (12.6) | (6.2 ± 0.3)·107 (4.1) |
| Enterococcus faecium DOS3 | (1.0 ± 0.2)·109 (100) | (1.5 ± 0.1)·108 (15.0) | (5.9 ± 0.1)·107 (5.9) | (3.4 ± 0.1)·107 (3.4) |
| Micrococcus endophyticus DOS4 | (3.2 ± 0.3)·109 (100) | (6.7 ± 0.4)·108 (20.9) | (1.7 ± 0.1)·108 (5.3) | (7.7 ± 0.4)·107 (2.4) |
| Enterococcus casseliflavus DOS5 | (1.2 ± 0.1)·109 (100) | (1.1 ± 0.1)·108 (9.2) | (4.7 ± 0.3)·107 (3.9) | (3.7 ± 0.2)·107 (3.1) |
| Bacillus subtilis DOS6 | (1.9 ± 0.1)·109 (100) | (5.2 ± 0.2)·108 (27.4) | (1.1 ± 0.1)·108 (5.7) | (6.2 ± 0.4)·107 (3.2) |
| Alcaligenes faecalis DOS7 | (4.2 ± 0.4)·109 (100) | (2.2 ± 0.1)·109 (52.4) | (1.5 ± 0.1)·109 (35.7) | (1.3 ± 0.1)·109 (31.0) |
| No | Biocide | MIC, ppm | MBC, ppm |
|---|---|---|---|
| 1 | DDAC | 900 | 900 |
| 2 | ADBAC | 600 | 600 |
| 3 | PHMG | 500 | 500 |
| 4 | CHG | 1000 | 2000 |
| 5 | “Latrina” (DDAC + PHMG) | 1350 | 2700 |
| Biological Product | Aerobic Conditions | Anaerobic Conditions | ||
|---|---|---|---|---|
| O2 Consumption Rate, mmol O2/mL FS/Day (in % of Control) | The Number of Viable Cells, CFU/mL | CO2 Formation Rate mmol CO2/mL FS/Day (in % of Control) | The Number of Viable Cells, CFU/mL | |
| Control | 0.0092 (100) | (1.4 ± 0.1)·106 (100) | 0.0004 (100) | (1.2 ± 0.1)·106 (100) |
| DOS1 | 0.0190 (206.5) | (6.5 ± 0.2)·107 (4643) | 0.0082 (2050) | (1.1 ± 0.1)·107 (916.7) |
| DOS2 | 0.0190 (206.5) | (1.4 ± 0.1)·107 (1000) | 0.0069 (1725) | (3.4 ± 0.1)·106 (283.3) |
| DOS3 | 0.0197 (214.1) | (2.2 ± 0.2)·107 (1571) | 0.0086 (2150) | (4.2 ± 0.2)·106 (350.0) |
| DOS4 | 0.0193 (209.8) | (5.1 ± 0.1)·107 (3643) | 0.0089 (2225) | (6.1 ± 0.1)·107 (5083.3) |
| DOS5 | 0.0194 (210.8) | (6.2 ± 0.3)·107 (4429) | 0.0082 (2050) | (4.1 ± 0.3)·107 (3416.7) |
| DOS6 | 0.0198 (215.2) | (6.4 ± 0.2)·107 (4571) | 0.0077 (1925) | (5.0 ± 0.2)·107 (4167.7) |
| DOS7 | 0.0205 (222.8) | (5.9 ± 0.2)·108 (42,143) | 0.0079 (1975) | (8.5 ± 0.2)·107 (7083.3) |
| Treatment | Aerobic Process | Anaerobic Process |
|---|---|---|
| Control 1: FS without added “Latrina“ | 5690 | 5690 |
| Control 2: FS with added “Latrina” | 2027 | 4500 |
| FS with added “Latrina” + DOS1 | 4310 | 4880 |
| FS with added “Latrina” + DOS2 | 4650 | 4930 |
| FS with added “Latrina” + DOS3 | 4730 | 5010 |
| FS with added “Latrina” + DOS4 | 5120 | 5140 |
| FS with added “Latrina” + DOS5 | 4950 | 4850 |
| FS with added “Latrina” + DOS6 | 5600 | 4900 |
| FS with added “Latrina” + DOS7 | 5630 | 5250 |
Publisher’s Note: MDPI stays neutral with regard to jurisdictional claims in published maps and institutional affiliations. |
© 2022 by the authors. Licensee MDPI, Basel, Switzerland. This article is an open access article distributed under the terms and conditions of the Creative Commons Attribution (CC BY) license (https://creativecommons.org/licenses/by/4.0/).
Share and Cite
Loiko, N.; Kanunnikov, O.; Serdyukov, D.; Axelrod, V.; Tereshkin, E.; Vishnyakova, A.; Litti, Y. Didecyldimethylammonium Chloride- and Polyhexamethylene Guanidine-Resistant Bacteria Isolated from Fecal Sludge and Their Potential Use in Biological Products for the Detoxification of Biocide-Contaminated Wastewater Prior to Conventional Biological Treatment. Biology 2022, 11, 1332. https://doi.org/10.3390/biology11091332
Loiko N, Kanunnikov O, Serdyukov D, Axelrod V, Tereshkin E, Vishnyakova A, Litti Y. Didecyldimethylammonium Chloride- and Polyhexamethylene Guanidine-Resistant Bacteria Isolated from Fecal Sludge and Their Potential Use in Biological Products for the Detoxification of Biocide-Contaminated Wastewater Prior to Conventional Biological Treatment. Biology. 2022; 11(9):1332. https://doi.org/10.3390/biology11091332
Chicago/Turabian StyleLoiko, Nataliya, Oleg Kanunnikov, Dmitriy Serdyukov, Vladimir Axelrod, Eduard Tereshkin, Anastasia Vishnyakova, and Yuriy Litti. 2022. "Didecyldimethylammonium Chloride- and Polyhexamethylene Guanidine-Resistant Bacteria Isolated from Fecal Sludge and Their Potential Use in Biological Products for the Detoxification of Biocide-Contaminated Wastewater Prior to Conventional Biological Treatment" Biology 11, no. 9: 1332. https://doi.org/10.3390/biology11091332
APA StyleLoiko, N., Kanunnikov, O., Serdyukov, D., Axelrod, V., Tereshkin, E., Vishnyakova, A., & Litti, Y. (2022). Didecyldimethylammonium Chloride- and Polyhexamethylene Guanidine-Resistant Bacteria Isolated from Fecal Sludge and Their Potential Use in Biological Products for the Detoxification of Biocide-Contaminated Wastewater Prior to Conventional Biological Treatment. Biology, 11(9), 1332. https://doi.org/10.3390/biology11091332

